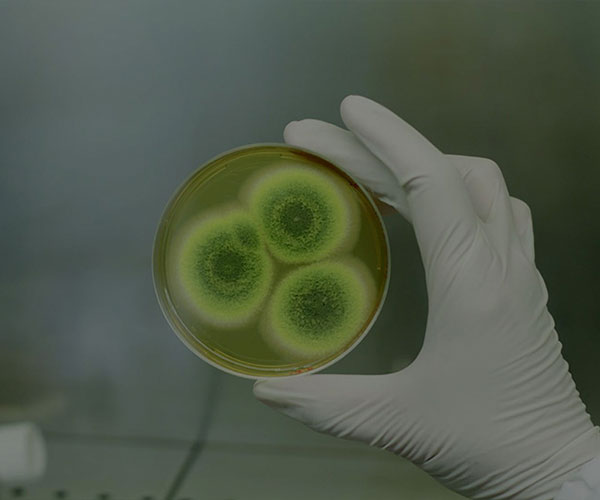

产品应用
查看更多
在制药行业中,分离是指将物质混合物分离为其各组分的过程。这一过程对众多原料药及化学品的生产至关重要。分离方法多样,具体方法的选择取决于待分离物质的具体特性。
离心分离是常见的分离方法之一。这是一种完全的物理分离过程,基于混合物中互不相溶的固、液相组分之间的密度差异,在同一离心力场中实现错流分离。它能完成固-液、固-液-液、液-液、固-液-固等多种混合液型的两相及三相分离。
经过数十年的工业发展,卧螺离心机与碟式分离机被认为是应用离心分离技术的两大代表机型:
在生物制药领域:卧螺离心机常用于发酵液的菌体/细胞收获;而碟式分离机则多用于发酵液的澄清以及萃取溶剂的分离与回收。
在化学制药领域:卧螺离心机通常用于反应物的收获与脱水,以及母液的澄清与回收;而碟式分离机则主要用于液态化学产物的澄清。
如果您身处制药行业,就会明白分离机与卧螺离心机必不可少。市场上有种类繁多的设备,各自拥有独特的功能与优势。在为您的应用选择合适机型时,务必考虑您工艺的特定需求以及待处理物料的性质。选择合适的分离机或卧螺离心机,是确保生产设施高效、稳定运行的关键。


非活疫苗(如流感、霍乱、肝炎、破伤风及白喉疫苗)是世界免疫计划的重要组成部分。这类疫苗通常基于灭活病原体、纯化蛋白或多糖,其生产过程需要精密制造以确保有效性与安全性。华鼎分离机提供先进的离心解决方案,旨在应对非活疫苗生产在纯化、分离与浓缩方面的独特挑战。 离心机在非活疫苗生产中的作用 离心机对于确保生产过程符合严格的质量、安全及法规标准至关重要。借助先进的离心技术,生产商能够在显著提升产线效率与可靠性的同时,获得稳定、高质量的结果。 离心机用于将活性成分浓缩至所需的效价水平,确保疫苗产品的剂量一致且有效。 效价可调:将活性成分浓缩至符合疫苗配方要求的精确规格,保证剂量的一致性与效力。 体积减量:通过减少液体体积,简化下游加工和制剂步骤,节约时间和资源。 可扩展的解决方案:从研发用的小批量生产到工业级制造,华鼎离心机设计用于处理不同生产规模,同时保持高效率。 在非活疫苗生产中的具体应用 离心机有助于关键组分的高效分离、纯化与浓缩,确保疫苗符合严苛的质量、安全与有效性标准。 1. 流感疫苗流感疫苗依赖于对血凝素(HA)和神经氨酸酶(NA)等关键病毒蛋白的精确提取。离心机能够从鸡胚或细胞培养系统中分离这些蛋白,高速离心过程可有效去除杂质与碎片,为疫苗配方提供纯净的抗原。先进的离心机型还具备良好的可扩展性,能同时满足季节性流感疫苗和大规模疫情应对的高效生产需求。 2. 霍乱疫苗霍乱疫苗旨在中和细菌毒素,需要对其进行精密的分离与纯化。离心机可高效分离并纯化这些毒素亚单位,同时去除不需要的细菌碎片和副产物,从而提升疫苗安全性。自动化的离心系统进一步确保了批次间的一致性,使其成为实现大规模疫苗生产与分发均一性不可或缺的工具。 3. 甲型与乙型肝炎疫苗甲肝和乙肝疫苗依赖于重组蛋白,如乙肝表面抗原(HBsAg)。离心机能高效地从生产培养物中提取这些蛋白,并通过高速离心纯化抗原,确保其免疫原性和稳定性。此外,离心系统可浓缩活性成分,实现精确的剂量控制,并减少下游处理时间,从而提升整体生产效率。 4. 百日咳(百白破)疫苗无细胞百日咳疫苗依赖于从百日咳杆菌培养物中精确提取和纯化抗原或灭活毒素。离心机能够准确提取目标抗原或毒素,并保持其完整性与生物活性。先进的多区分离技术可高效去除污染物,得到高纯度的疫苗。温和的进料与排料系统能保护脆弱的抗原,在加工过程中维持其品质与效力。 5. 破伤风与白喉疫苗破伤风和白喉疫苗使用经化学灭活处理的细菌类毒素制成。离心机通过澄清细菌培养液发挥关键作用,高效去除细胞碎片并分离灭活的毒素。随后,这些类毒素会经过进一步纯化,以确保其作为疫苗成分的安全性和有效性。为维持无菌状态,可采用蒸汽灭菌的离心机系统,提供无菌工艺条件,大限度降低污染风险,保障高质量生产。 6. 肺炎球菌疫苗肺炎球菌疫苗旨在预防肺炎链球菌感染,其生产依赖于特定荚膜多糖的分离。离心机负责分离和纯化这些多糖,随后将其与载体蛋白结合以制备疫苗。高速离心能有效浓缩这些成分,确保批次间剂量的一致性。此外,先进的离心机型能够娴熟处理针对多种菌株的多价肺炎球菌疫苗的复杂生产工艺。 华鼎离心解决方案的优势 优越效率 自动化复杂的分离流程,显著减少人工投入与生产时间。 品质稳定通过精密可靠的分离,确保批间一致性。 合规保障符合GMP及生物安全法规等生产标准。 节能设计优化能耗,在不牺牲性能的前提下实现更低运行成本。 为何选择华鼎分离机械用于非活疫苗生产? 凭借在制药级分离技术领域数十年的专业积累,华鼎分离机已成为非活疫苗生产商信赖的伙伴。我们先进的离心系统集精密、高效与可靠于一体,满足行业的高标准。无论您生产流感、霍乱、肝炎还是其他疾病的疫苗,华鼎都能提供定制化解决方案,优化您生产流程的每一步。 欢迎探索华鼎分离机的高端离心系统产品系列,了解我们如何助您优化疫苗生产。
概述 活疫苗(如麻疹、腮腺炎、风疹、黄热病、水痘、结核病/卡介苗、斑疹伤寒及轮状病毒疫苗)的生产是一个精细且要求极高的过程,需要先进设备以达到安全、高效和纯度的高标准。华鼎分离机提供创新的离心解决方案,专为满足活疫苗生产的严格要求而设计。 离心机在活疫苗生产中的作用 细胞收获 华鼎离心机能高效地从生长培养基中回收活细胞或微生物,这是疫苗生产的关键步骤。其温和而有效的分离过程能极大限度减少对细胞的损伤,保持其活力和生物活性,这对活疫苗的效力至关重要。 纯化与澄清 收获后的纯化对于去除细胞碎片、蛋白质和其他不需要的副产物等杂质至关重要。华鼎离心机配备精密系统,可在不损害疫苗完整性的前提下实现这一目标,从而提升产品的质量与安全性。 满足不同规模的生产需求 无论是小规模研究批次还是大规模工业化生产,华鼎都能提供适应不同生产能力的离心解决方案。其高速、连续运行的离心机都可在不牺牲性能或产品质量的前提下,实现生产规模的无缝扩大。 对生物材料的温和处理 活疫苗通常涉及敏感的生物培养物。华鼎离心机设计有液压密封进料系统和温和的排料机制等特性,以极大限度减少剪切力,保护活细胞和病毒的脆弱特性。 无菌与生物安全保障 活疫苗生产要求严格的无菌条件以避免污染。华鼎离心机构建了以下保障:蒸汽灭菌功能:支持原位清洗和灭菌,无需拆卸设备。封闭式系统:采用全密封设计,保持无菌环境,并保护操作人员免受有害生物制剂的暴露。 按疫苗类型的应用细分 病毒性疫苗(麻疹、腮腺炎、风疹、水痘、黄热病) 病毒性疫苗的生产需要对病毒培养物进行精确的分离与澄清,以维持活病毒颗粒的效力和有效性。华鼎的高速离心机专为此类生产设计,具备以下优势:高分离效率:确保彻底去除杂质,同时保护病毒活性。温和的产品处理:在加工过程中保护敏感的病毒颗粒免受损伤。无菌保证:蒸汽灭菌型号可在全程维持无菌条件。 细菌性疫苗(结核病卡介苗、斑疹伤寒疫苗) 细菌性疫苗的生产依赖于对细菌培养物的精心处理,以保持其活力和免疫原性。华鼎的卧螺离心机在此领域表现优良。强大的处理性能:高效处理高固含量的细菌培养物。全密闭系统:防止交叉污染,确保生物安全。可定制特性:可根据特定菌株和生产规模提供定制配置。 轮状病毒疫苗 对于轮状病毒等儿科疫苗而言,获得理想的得率与纯度至关重要。华鼎的碟式离心机提供高速分离技术。多区分离:增强组分的分层,确保产品的高纯度。连续运行:支持大规模、稳定通量的生产。高能效:在保持产出的同时,降低运行成本。 华鼎疫苗生产离心机的先进特性 1.蒸汽灭菌型号 华鼎离心机配备集成式蒸汽灭菌设计,无需拆卸即可简化清洁与灭菌流程。这确保了生产全程的无菌条件,对疫苗安全和法规符合性至关重要。通过消除人工清洁步骤,这些型号减少了停机时间,提高了生产效率,是严格要求无菌环境的理想选择。 2.全密闭进料系统 华鼎离心机的全密闭进料系统为处理敏感或有害生物材料提供完全封闭的环境。该设计在整个操作过程中保持无菌状态,在确保活疫苗完整性的同时,保护操作人员及周边环境。全密闭系统还能极大限度减少物料处理过程中的剪切力,保护脆弱细胞或病毒颗粒的活性。 3.自清洁技术 华鼎离心机配备先进的自清洁机构,可自动清除系统中的废物与污染物。此功能减少了人力需求,延长了维护周期,并支持连续运行。通过保持离心机长期清洁与可运行状态,自清洁技术显著提升了整体生产率,尤其适用于高通量生产线。 4.高分离精度 华鼎的多区分离系统在疫苗生产过程中实现了组分分层精度。这些系统能够精确去除杂质、细胞碎片及不需要的副产物,确保产品的高纯度与高效率。高速分离能力也优化了得率,减少了浪费,提升了成本效益。 为何选择华鼎作为活疫苗生产合作伙伴? 每一款疫苗的生产工艺都是独特的,华鼎深谙定制化解决方案的必要性。我们提供可根据特定生产需求进行设计的离心机,无论是用于小规模试点项目还是大规模工业化生产。定制选项包括处理能力调整、专用进料系统以及先进的控制功能,以适应多样化的应用场景。 华鼎分离机致力于通过引入先进的离心解决方案推动疫苗生产进步。凭借数十年的分离技术经验,华鼎为疫苗生产商提供的专业知识、可靠的设备与全方面的支持。无论您生产的是病毒性还是细菌性疫苗,华鼎离心机都能提供满足行业高标准所需的精度、可扩展性与安全保障。

大麻二酚(CBD)是工业大麻中发现的众多化合物之一,目前已知其具有一系列药用益处。近年来,CBD已变得非常流行,被提取并加工成多种产品,包括食品、CBD油甚至乳霜。其中普遍的消费形式是CBD油,它被用于治疗多种疾病,这主要归功于其作用于内源性大麻素系统的方式,且不会产生在许多国家非法的“致幻”效果。四氢大麻酚(THC)是导致这种“致幻”感的主要成分,而CBD不仅能避免这种影响,还有助于减轻THC的精神活性作用。 CBD与THC的作用机制有本质不同。CBD不直接刺激CB1和CB2受体,其主要影响是通过作用于血清素、腺苷和香草素等其他受体实现的。例如,CBD对TRPV-1受体的刺激会调节体温、炎症和痛觉感知。此外,CBD还能抑制直接作用于CB1受体的FAAH酶的功能,从而减弱THC的精神活性效应。这些特性使得CBD在世界范围内引发了行业医学界的广泛兴趣。 CBD提取方法世界多地(包括印度、中国及部分西欧国家)合法种植的各种工业大麻品系是提取CBD的常用原料。其中,“Fedora 17”是受欢迎的品系之一,因其THC含量极低,从中提取的CBD几乎不具有精神活性。由这类大麻制成的CBD油在世界大多数地区(包括美国所有50个州)是合法的,这得益于其可忽略不计的THC含量。 常见的提取方法主要有四种:CO2萃取法橄榄油萃取法干冰萃取法溶剂萃取法 在工业化大规模生产中,乙醇萃取法因其高效率与低成本成为普遍的CBD提取方法。过滤是生产大麻浓缩物过程中的常见步骤。 离心技术在CBD提取中的应用 离心分离是高效分离提取物与固体生物质材料的有效方法。该萃取过程可在上游容器中进行。 过滤步骤的目标在于提高澄清度、增强效价、提升稳定性并优化整体消费体验。对此环节的普遍要求是,在保证目标活性成分得率的同时,减少提取物中的固体及无用物质含量。 客户案例2017年,华鼎为一客户安装了一台卧螺离心机和一台分离机,专门用于从工业大麻中提取CBD。 用于工业大麻CBD提取的卧螺离心机

高效温和的离心分离解决方案 在制药领域,维生素、动植物提取物、抗生素、酶、激素及其他生物制剂等高价值活性成分通常具有高度敏感性和珍贵性。华鼎分离机提供气密与防爆设计的分离机与卧螺离心机,确保对这些成分进行温和、高效的提取,为医疗进步奠定重要基础。 无论是液-液、液-液-固还是液-固分离,无论是单级还是多级操作,也无论是顺流、逆流还是错流原理,华鼎分离机都能提供工艺方案覆盖。 适用于各类提取物的设备 我们的分离机与卧螺离心机广泛应用于以下高价值制药成分的提取与纯化: 生物碱 吗啡、可待因、咖啡因、可卡因、麦角碱、奎宁、利血平、洋地黄等 草本药物 大麻二酚(CBD)、特殊药剂、药用茶剂、精油与香料、各类植物精油、香精、抗生素 青霉素、红霉素、四环素、杆菌肽、克拉维酸、环孢素等 他汀类药物 洛伐他汀、普伐他汀等 甾体/激素 皮质类固醇、生长激素、睾酮等 器官提取物 胰岛素 胰酶 胎盘提取物等 果胶 维生素 芳香物质 华鼎设备凭借其精密分离、温和处理及高度可靠性,成为从天然原料中规模化提纯高活性、热敏性药物成分的理想选择,助力制药企业提升产品纯度、得率与生产安全性。

面向未来的高效生物分离技术 生物制药致力于研发未来的高科技药物,其生产所涉及的高度敏感的生物材料,要求必须有相应的温和保护性工艺。在这些高度精密的生产过程中,华鼎分离机的离心分离技术扮演着关键角色。无论是无菌工艺管理、在线清洗能力、全密闭的物料处理、温和的产品对待、可靠的GMP合规性,还是活性成分的高效回收与稳定的工艺放大,生物技术领域的要求都极为严苛。华鼎分离机专为生物技术应用而设计的分离机与卧螺离心机,代表着对这些要求的可靠满足。 华鼎设备在生物药剂回收中的应用 华鼎的分离机与卧螺离心机广泛应用于以下高价值生物制品的分离、纯化与回收: 疫苗 人用疫苗:甲型/乙型肝炎、流感、脑膜炎C型、肺炎球菌、腮腺炎/麻疹/风疹(MMR)、脊髓灰质炎、白喉、破伤风、百日咳等。 兽用疫苗:口蹄疫等。 胰岛素与酶制剂 胰岛素:从生物质中提取。 酶制剂:淀粉酶、蛋白酶、脂肪酶、纤维素酶等。 发酵剂与血液制品 发酵剂(细菌培养物):乳杆菌、明串珠菌、链球菌、双歧杆菌等。 人血液蛋白:冷沉淀(凝血因子VIII)、纤维蛋白原、球蛋白、白蛋白等。 合成生物药物 药物蛋白:干扰素、白细胞介素等。 肝素。 华鼎解决方案凭借其无菌设计、温和分离与优异的工艺稳定性,为从研发到大规模生产的各个环节提供可靠支持,助力生物制药企业提升产品质量、生产安全与经济效益。